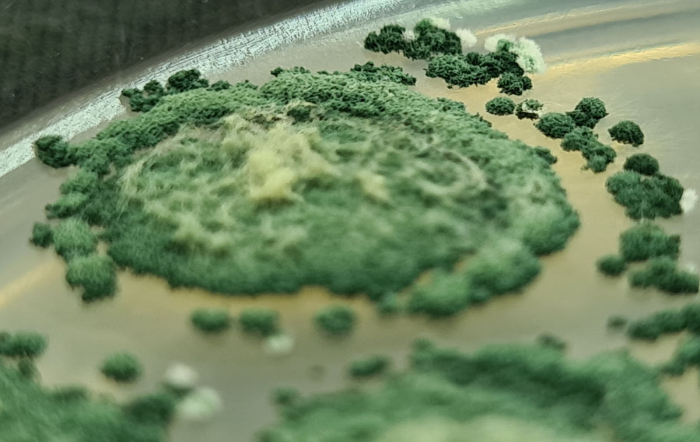
Zayame Vegette_Embrapa_fotor

Segundo a Embrapa Meio Ambiente, método pode ajudar a ampliar esse mercado no País
Um novo protocolo pode ajudar na análise da qualidade dos bioprodutos à base de bacilos (bactérias) utilizados nas lavouras para combater doenças e pragas, que é um dos principais gargalos para a expansão do controle biológico no Brasil. Desenvolvido pela Embrapa Meio Ambiente (SP), consiste na quantificação do número de estruturas viáveis dos microrganismos, expresso em unidades formadoras de colônias por mililitro ou grama (UFC/mL ou UFC/g).
Além de garantir mais segurança a agricultores e consumidores, a metodologia pode aumentar a adoção e colaborar com a ampliação do mercado para os produtos biológicos à base de bacilos no País. De acordo com o pesquisador da Embrapa Meio Ambiente Wagner Bettiol, a mensuração por unidades formadoras de colônias é usada em microbiologia para estimar o número de bactérias viáveis.

Mercado de agentes de controle biológico cresceu 70% no Brasil nos últimos anos, graças às demandas dos consumidores por produtos mais saudáveis. Foto: Zayame Vegette
“Essa quantificação é indispensável para avaliar a qualidade do produto e determina a concentração adequada do microrganismo para garantir a sua eficiência. Se os valores obtidos na análise forem inferiores aos informados no rótulo do produto registrado no Ministério da Agricultura, Pecuária e Abastecimento (Mapa), há indicação de que o produto está fora do padrão e, portanto, sujeito aos procedimentos de fiscalização”, explica Bettiol.
Segundo a engenheira agrônoma da Ballagro Agro Tecnologia Ltda. Zayame Vegette, o protocolo pode nortear as empresas na fase de desenvolvimento de produtos biológicos, visto que os valores obtidos permitem fazer os acertos necessários durante a produção e ao longo dos processos de registros do produto, além de fornecer informações fundamentais para as recomendações de rótulo.
Em relação à produção on farm ou “caseira”, largamente utilizada no País, cujos produtos não são comercializados, não há necessidade de garantia mínima do número de unidades formadoras de colônias por mL ou por grama. Mas, segundo Bettiol, os resultados podem auxiliar os agricultores na definição dos volumes a serem aplicados para poder atingir o efeito desejável no controle das doenças e das pragas, bem como colaborar na melhoria do processo de fermentação das bactérias.
Expansão

A mensuração por unidades formadoras de colônias é usada em microbiologia para estimar o número de bactérias viáveis. Foto: Zayame Vegette
O registro de produtos biológicos no Mapa mostra a expansão desse mercado no Brasil. De 27, em 2011, passou para 137, em 2018; 200, em 2019 e alcançou 500, em 2022. Esses dados indicam a tendência de adoção crescente de tecnologia mais sustentável pelos agricultores. Os produtos formulados à base de bactérias e os obtidos via fermentação on farm são os mais utilizados no controle de doenças e de pragas das plantas no Brasil.
Além da eficiência, eles apresentam outra característica importante: o fato de formarem endósporos (estrutura de resistência), que permitem sua sobrevivência por longos períodos no ambiente, além de aumentar a sua vida de prateleira para período superior a dois anos.
Qualidade
Segundo a Associação Brasileira das Empresas de Controle Biológico (ABCBio), atualmente vinculada à CropLife Brasil, o mercado de agentes de controle biológico cresceu mais de 70% no Brasil nos últimos anos. Impulsionado principalmente pelas demandas dos consumidores por produtos mais saudáveis, enfrenta ainda como gargalo o controle de qualidade dos bioprodutos comerciais e caseiros.
“A padronização de metodologias para a avaliação da qualidade e conformidade é fundamental para proteger a saúde dos produtores e dos consumidores”, esclarece Bettiol.

O registro de produtos biológicos no Mapa saltou de 27, em 2011, para 500, em 2022. Foto: Zayame Vegette
O novo protocolo é resultado do projeto Qualibio, iniciado em 2008, para desenvolver metodologias para análise da qualidade de produtos biológicos. As metodologias desenvolvidas estão voltadas para a avaliação de bactérias do gênero Bacillus e também de fungos do gênero Trichoderma, que são os principais agentes de controle biológico de doenças de plantas no Brasil. Mas podem ser estendidas para outros microrganismos utilizados como agentes de biocontrole.
O Qualibio foi coordenado pela Embrapa Meio Ambiente e desenvolvido em parceria com a Embrapa Arroz e Feijão, Instituto Biológico de São Paulo, Empresa de Pesquisa Agropecuária de Minas Gerais (Epamig), Universidade Federal de Pelotas (UFPel) e Comissão Executiva do Plano da Lavoura Cacaueira (Ceplac).